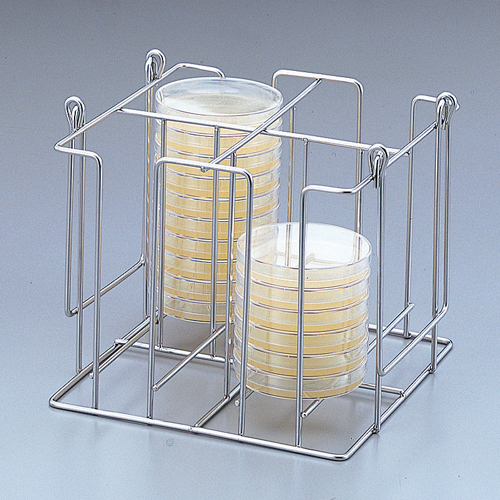

培养皿架 シャーレラック RACK FOR DISH-3-233-01|||3-233-02|||3-235-01|||3-235-02
※目录刊载页:易购安实验用仪器・耗材目录6000号277页
特点
- 1/2型可将整个培养皿架放入培养箱中。
- W型可一次保管・移动大量培养皿。
规格
- 材质:不锈钢(SUS304)
- 可存放的培养皿:φ90×15mm、F型/40只、F1/2型/20只、FW型/80只、FW1/2型/40只

相关商品
| 编号 | 型号 | 尺寸(mm) | 库存 | 备考 |
| 3-233-01 | F型 | 230×105×365 | (联系我们) | |
| 3-233-02 | F1/2型 | 230×105×185 | (联系我们) | |
| 3-235-01 | FW型 | 230×210×365 | (联系我们) | |
| 3-235-02 | FW1/2型 | 230×210×185 | (联系我们) |
商品属性
| 商品属性 | |
|---|---|
| 商品名称 | 培养皿架 シャーレラック RACK FOR DISH-B00210062-b |
| 型号 | 3-233-01|||3-233-02|||3-235-01|||3-235-02 |
| 类别 | 设备・保管・搬运|||收纳・整理・保管 |
| 特点 |
|
| 规格 |
|
| 备注 | ※目录刊载页:易购安实验用仪器・耗材目录6000号277页 |


商品咨询
- 没有您需要的答案?您可以提问,客服将在1个工作日内回复您。
- 订单查询、物流配送、商品损坏等售后问题,您可以拨打7x12小时客服电话:400-666-2192 。